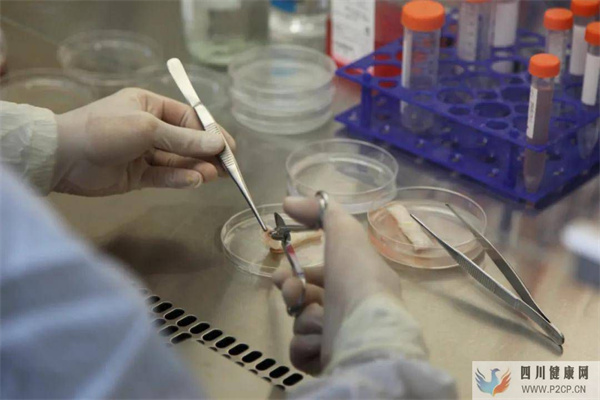
细胞到底能存多久？今天就来讲讲细胞冻存那些事儿～(干细胞冻存价格)(图1)

细胞到底能存多久?今天就来讲讲细胞冻存那些事儿~(干细胞冻存价格)
原标题:细胞到底能存多久?今天就来讲讲细胞冻存那些事儿~
我们的身体是一个巨大的精密仪器,每一个器官都是其中重要的组成零件,细胞就是其中最基本也是最重要的元件。
如同机器需要定期维修、更换,人体也有自我修复机制,然而此现象是会随着年龄的增长而不断在身体里累积,细胞的自我再生能力也会随着年龄的增加而衰退。
如今很多人都为自己的健康做好了长远规划,选择新型的个人健康管理方式——冻存免疫细胞。但是也有很多疑问:细胞冻存可以冻存多长时间?细胞复苏后活性如何?什么时候冻存细胞的质量最高?
今天就来带大家细数细胞冻存发展简史,带大家一起来了解一下细胞冻存的那些事儿。
细胞冻存技术初见雏形
1776年,Spallanzani最早发表了“冷”处理对“细胞”生命活动影响的报道。
十九世纪中后叶,许多早期的工作者重复研究了低温处理对精子活动的影响,得出了和 Spallanzani相似的结论,即“冷不能杀死精子”。
1900年前后,科学家基本上肯定了生物成份能够在零下温度储存的事实。
20世纪50年代,Luyet等多位学者发现了电解质浓度对储存细胞的损伤作用,他们的基本结论是,电解质浓度增大是造成储存细胞损伤的主要原因。
细胞冻存技术不断发展
60年代,美国纽约血液中心Rowe实现了红细胞的低温保存。1980年,他将在液氮温度下保存了12年的红细胞复苏后进行检查,没有发现任何生化和功能上的变异,从而从实践上证明了生物材料可以在低温下长期存活。
70年代,Mazur等首先根据中国仓鼠组织培养细胞的低温保存实验数据分析,提出关于冷冻损伤的两因素,即冰晶损伤和溶液损伤。
80年代以来,理学和工程学进入低温保存研究领域,低温工程理论及实用设计原理的不断更新及应用,低温生物学的研究快速发展。
20世纪以来,人类的科学研究进入细胞水平阶段,开始对生物和作为食品原料的生物材料进行低温保存处理。到了20世纪末,随着科学方法的不断进步以及冷冻方法的不断完善,低温保存技术广泛地应用到了临床上。
细胞存储知多少
1、细胞冻存可以冻存多长时间?
理论上可永久储存。研究表明,细胞冷冻储存在-70℃冰箱中可以保存一年之久;细胞储存在液氮中,温度达-196℃,只要保存得当,理论上储存时间是无限的。
2、什么时候冻存细胞的质量最高?
人体免疫力在20岁左右达到高峰,随着年龄的增长,免疫细胞的活性越来越低,随之而来的就是疾病发生率逐年上升。
因此,预先将健康的免疫细胞存储在-196℃的深低温液氮罐中,待到需要之时,即用即取,方便安心。今天的细胞永远比明天的年轻,最好的储存时间就在当下!
存储细胞 存储健康
随着现代医学的发展,科学家们对细胞前沿技术不断探索与研究,细胞科技已经成为人类生命健康的有力保障,并在健康管理与疾病治疗领域发挥了重要作用。
将健康充满活力的免疫细胞存储起来,成为越来越多的人为未来人生保驾护航的重要手段,存储免疫细胞就是为自己投资一份健康财富!快来国卫生物存储你的免疫细胞吧!返回搜狐,查看更多
责任编辑:





